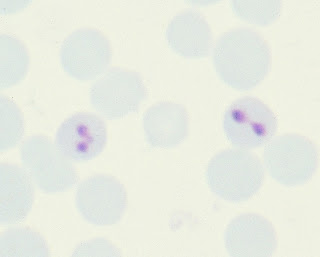

عدوى البابيزيا_babesiosis
بسم الله الرحمن الرحيم
التعريف بالمرض :عدوى البابيزيا عبارة عن مجموعة من الأمراض التي تنتقل عن طريق القراد وتصيب مجموعة كبيرة من الحيوانات الأليفة والبرية واحانا تصيب الإنسان، يسببها طفيل وحيد الخلية يعيش داخل كرات الدم الحمراء من جنس بابيزيا.عدوى البابيزيا لها عدة اشكال منها الشكل الحاد و يطلق عليه(babesiosis) و يتميز بالنمو والتكاثر السريع للطفيل في دم العائل مما يسبب تكسير كرات الدم الحمراء على نطاق واسع مما يؤدى إلى فقر الدم واليرقان وظهور الهيموجلوبين في البول وتضخم الطحال وحمى شديدة وغالبا ما يفضى إلى الموتاما الشكل تحت الاكلينيكي او المزمن و يطلق عليه (babesiasis) فانه يصعب تمييزها إكلينيكيا وتكون مصحوبة بفقر الدم ودرجات متفاوتة من الهزا ومن الممكن ان يصحبها شفاء للحيوان في حالة العدوى الاولية للطفيلهناك أكثر من 71 نوعا من البابيزيا معروفا للآن، من بينهم 18 نوعا يسبب الأمراض في الحيوانات المستأنسة.عدوى البابيزيا تصنفها منظمة للأوبئة العالمية بباريس ضمن القائمة B"المسبب للمرض :هي عبارة عن طفيليات وحيدة الخلية من جنسbabesia عائلة babesidae رتبة بيروبلازميدا "Order Piroblasmidaطفيل البابيزيا يعيش داخل كرات الدم الحمراء حيث تظهر داخل كرات الدم الحمراء كأجسام غير ملونة كمثرية الشكل متواجدة على هيئة أزواج ملتصقة نتيجة انقسامها بالانقسام الثنائي البسيط. عند الصبغ صبغة جيمسا- صبغة ليشمان يصطبغ السيتوبلازم باللون الأزرق بينما يصطبغ الكروماتين باللون الأحمر.
![]() |
| Bovine, blood smear. Two erythrocytes contain pairs of ovoid Babesia bovis. |
دورة حياة البابيزيا لها مرحلتان، في الأولى تتكاثر تكاثراً لا جنسيا بالانقسام الثنائي البسيط في كرات الدم الحمراء في العائل الفقاري وفي المرحلة الثانية تتكاثر في إناث القراد بواسطة الاسبروجونى "Sporogeny -التكاثر التجرثمي" حيث يتم اتحاد الجاميتات Gametes المذكرة و المؤنثة لتكوين الزيجوت فى عملية تنتهى بتكوين الطور المعدي "الأسبوروزيت"، الأسبوروزيت قد يتطور في الغدد اللعابية في اليرقات والحوريات Nymphs والحشرات البالغة أو قد يقتصر ذلك على كلا من الحوريات والحشرات البالغة فقط اعتمادا على نوع القراد ونوع البابيزيا، فعلى سبيل المثال في حالة بابيزيا باىجيمنا فان الحوريات والطور البالغ فقط يمكنها نقل العدوى.
الوبائية :عدوى البابيزيا منتشرة على نطاق واسع عالميا مرتبطا بانتشار القراد الناقل في المناطق الحارة وتحت الحارة و في الشمال الأفريقي بما فيه مصر والشرق الأوسط وجنوب أوربا وكذلك جنوب أمريكاتم اكتشاف بابيزيا بوفيس بواسطة بابيز عام 1888 في رومانيا ومنذ ذلك الحين تم وصف العديد من الأنواع الأخرى. سجل المرض للمرة الأولى في مصر عام 1947القابلية :جميع الحيونات المستانسة كلابقار و الجاموس و الاغنام و الماعز و الخيول و الخنازير و القطط و الكلاب و البرية و حيوانات التجارب و الانسانبالنسبة للماشية الأبقار هي العائل الرئيسي لعدوى البابيزيا بالماشية ولكن الجاموس المائي والجاموس الأفريقي وبعض الحيوانات ذات الحافر الأخرىUngulates قد تصاب أيضا بالعدوى، ومثل هذه العوائل قد تكون خازنة للعدوى بشكل غير مؤثر. يوجد على الأقل 6 أنواع من البابيزيا مسئولة عن عدوى البابيزيا بالماشية أكثرهم أهمية وانتشارا بالمناطق الحارة وتحت الحارة نوعان هما بابيزيا بوفيس Babesia bovis وبابيزيا باىجيمنا B. bigemina وتعتبر بابيزيا بوفيس بشكل عام هي الأكثر ضراوةبالنسبة للاغنام يوجد نوعان من البابيزيا مختلفان انتيجينيا هما بابيزيا موتاسي B. Motasi وهي اكبرهما حجما وأكثرهما ضراوة وتوجد بشكل منفرد أو على هيئة أزواج بكرات الدم الحمراء والثانية هي بابيزيا أوفيس B. ovis صغيرة الحجم على هيئة خاتم وقد يكون لها أشكال متنوعة.بالنسبة للخيول تصاب ب نوعين من البابيزيا هما تسببه ه بابيزيا إيكواى او بابيزيا كابالاى بالنسبة الى بابيزيا ايكواى هي الأكثر ضراوة لأنها تسبب إصابة 20% من كرات الدم الحمراء مما يؤدى إلى حدوث أعراض شديدة، وتتشابه بابيزيا ايكواى مع الثايليريا في أن لها دورة خارج كرات الدم الحمراء في الأنسجة الليمفية ذات الخلايا وحيدة النواة ولذلك يمكن تصنيفها على نحو دقيق كأحد أعضاء عائلة الثايليريا.اما بابيزيا كابالاىفانها تسبب أعراض مرضية اقل حدة وقد تكون غير محسوسة حيث أن 1% من كرات الدم فقط هي التي تصاب بالطفيل.و الجدول التالي يوضح انواع البابيزيا و اهميتها للحيوان :
| نوع البابيزيا | القراد الناقل | اماكن تواجدها | الحيوان المصاب |
| B. bigemina | boophilus microplusBo. AnnulatusBo. decoloratus | أفريقيا بما فيها مصر، أسيا، أمريكا، استراليا، جنوب أوروبا | الابقار و الجاموس |
| B. bovis | نفس أنواع القراد الناقل لبابيزيا باى جيمنا إضافة إلى نوع أكسوديز Ixodes spp | نفس مناطق انتشار البابيزيا باىجيمن | الابقار و الجاموس |
| B. major | Haemaphysalis punctata | أوربا وشمال أفريقيا | الابقار و الجاموس |
| B. divergens | Ixodes ricinus | شمال أوروبا | الابقار |
| B. jakimovi | Ixodes ricinus | روسيا | الابقار والمجترات البري |
| B. ovata | H. longicornis | اليابان | الابقار |
| B. occultans | H. marginatum rufipes | جنوب إفريقيا | الابقار والمجترات البري |
| B.motasi&B.ovis | Genera dermacentor,rhipicephalus,haemaphysalis and ixodes | شمال افريقيا و الشرق الاوسط و مصر و وجنوب أوربا وكذلك جنوب أمريك | الاغنام و الماعز |
| b.canis &b.gibsoni | Genera dermacentor,rhipicephalus,haemaphysalis and ixodes | افريقيا و اسيا و جنوب اروبا | الكلاب |
| B.equi | Genera dermacentor,rhipicephalus,haemaphysalis and ixodes | ي شمال ووسط وجنوب القارة الإفريقية وكذلك جنوب ووسط أمريكا وفي جنوب وشرق أوروبا وفى أسيا الصغرى والهند والشرق الأوسط بما فيه مصر. | الخيول |
العوامل التي تساعد على الاصابة :القابلية للإصابة بعدوى البابيزيا تقل بزيادة العمر ولكن شدة الإصابة تزداد بزيادة العمرالحيوانات العشار والهزيلة والحيوانات التي تعانى من ضغوط هي الأكثر حساسية للإصابتزداد نسبة الإصابة موسميا في فصل الصيف الذي يشهد نشاط القراد الناقل للمرضطرق انتقال العدوى :1_عن طريق القراد من انواع :القراد من عائلة الأوكسوديدFamily Ixodide و هيمافيسياليس Haemaphysalis، ريبيسيفاليس Rhipicephalus spp و درماسنتر dermacentor حيث تنتقل البابيزيا بشكل أساسي عن طريق المبايض من جيل لآخر Transovorially بينما نقل العدوى من طور لآخر من نفس الجيل Transstadially قد يحدث أيضا.القراد أحادى العائل من جنس بوفيلس Boophilus والمنتشر عالميا على نطاق واسع هو المسئول بصفة رئيسية عن نقل أهم نوعين من أنواع البابيزيا محل الاهتمام هنا وهما بابيزيا باىجيمنا وبابيزيا بوفيس، حيث أن اليرقات والحوريات والأطوار البالغة تتغذى على نفس العائل حتى تنزل الأنثى المتخمة التي تم تلقيحها إلى الأرض لوضع البيض.2_الابر و المحاقن الملوثة تساعد في انتقال المرض
![]() |
| Female Ixodes Scapularis |
الامراضية و دورة الحياة :

الاعراض المرضية:1_بالنسبة للماشية :فترة الحضانة تتراوح بين 1_3 اسابيع نسب النفوق فإنها تتباين بشدة حسب الوضع الوبائي وقد تصل إلى نسبة 50% أو أكثردورة المرض تتراوح فيما بين عدة أيام إلى 3 أسابيعالاعراض : الاعراض المرضية تاخذ ثلاث اشكال 1-الشكل الحاد و يتميز ب :حمى حادة تصل الى 41 درجة مئويةفقدان الشهية و خمول و ضعف عام وتوقف الاجترار و انخفاض حاد وتوقف في انتاج اللبنزيادة معدل ضربات القلب و معدل التنفس ملتحمة العين والأغشية المخاطية تكون محتقنة وذات لون احمر في البداية ولكن مع تكسير كرات الدم يتغير اللون إلى الشاحب المميز لفقر الدم. في المراحل الأخيرة يكون هناك يرقان شديدفي نهاية الشكل الحد يظهر اعراض اليرقان و اسهال وفقدان في وزن الحيوان وبول دموياجهاض الابقار العشارالأعراض العصبية نتيجة ركود كرات الدم الحمراء المصابة في الشعيرات الدموية للمخ كثيرة الحدوث في حالة بابيزيا أوفيس وتتميز إكلينيكيا بعدم الاتزان الذي يتبعه هوس Maniaوتشنجات Convulsions ثم شلل خلفي وإغماء والحالات التي تظهر عليها الأعراض العصبية تنتهي بالنفوقفي الحالات الحادة المميتة ينفق الحيوان بعد عدة أيام من ظهور الأعراض ولكن النفوق قد يحدث في خلال 24 ساعة فقط في الحالات الحادة الشديدة2_الشكل تحت الحاد :تكون الأعراض فيها اقل وضوحا حيث تكون الحمى معتدلة والبول المدمم غالبا لا يظهر وأحيانا يصعب الإحساس بأي أعراض.معدل إصابة كرات الدم الحمراء والأعراض الإكلينيكية في حالة الإصابة ببابيزيا داىفيرجنز يشابه مثيله في بابيزيا باىجيمنا إلى جانب أن الروث يكون مضغوط وصغير الحجم ممتد كساق الغليون pipe stem faeces يخرج بجهد كبير نتيجة انقباض العضلة العاصرة الشرجية.3_الشكل التحت اكلينيكي :فانه يصعب تمييزها إكلينيكيا وتكون مصحوبة بفقر الدم ودرجات متفاوتة من الهزا ومن الممكن ان يصحبها شفاء للحيوان في حالة العدوى الاولية للطفيل2_بالنسبة للخيول : دورة المرض تتراوح فيما بين 8-10ايام ونسب النفوق قد ترتفع لتصل إلى 35%.وله شكلان :1-الشكل الحاد :الحالات الحادة قد تشبه عدوى البابيزيا في الأبقار وتتميز بصفة رئيسية بعدم الحركة والرغبة في المشي بصورة مفاجئة مع حمى شديدة قد تصل إلى 40°م وغالبا ما تختفي خلال يوم وتصبح متقطعة كما يحدث oedema في منطقة المفصل فوق الحوافر كما قد يوجد الاستسقاء على الرأس وأسفل البطنكرات البرازfaecal ball تكون مغطاة بطبقة سميكة من المخاط وفي كثير من الحالات يعانى الحيوان المريض من آلام المغص. قد تبدو أعراض فقر الدم مع أغشية مخاطية باهتة اللون الوردي وقد يبدو اليرقان.ظهور الاعراض التنفسيةbrochitis و البول الهيموجلوبينى قد يظهر أيضا والحيوانات العشار المصابة يحدث لها إجهاض. الحالات الحادة الشديدة قد تنتهي بالنفوق بعد اقل من 48 ساعة من بداية ظهور الأعراض_ الأعراض تكون أكثر حدة في الخيول الأصغر سنا.2_الشكل المزمن : يتميز ب انيميا و هزال و الحيوانات التي شفيت تصبح حاملة للمرض وتعمل كمصدر لنقل العدوى للحيوانات الصحيحة، هذه الحيوانات لا يبدو عليها أي آثار للمرض باستثناء وجود الأجسام المضادة وأحيانا يتواجد الطفيل في الأوعية الدموية الطرفية حيث يمكن رصده ميكروسكوبيا. الحيوانات الحاملة للمرض إذا تعرضت لضغوط كالنقل أو التدريب العنيف فان أعداد الطفيل قد تتزايد لتعيد تنشيط العدوى.3_الحيوانات الاخري :عامة تتشابه الاعراض مع اعراض عدوى البابيزيا في الابقارالتشريح المرضي :في الحالات الحادة :احتقان معظم الاعضاء داخل الجسم مع وجود انزفة في انسجة هذة الاعضاء وممكن يصاحبة يرقان في الاغشية المغاطيةالطحال يكون متضخما بشكل واضح قد يصل في بعض الأحيان إلى عدة أضعاف حجمه، كما يكون هش سهل التفتت ولونه داكن وعند شقه يبدو سطح القطع كمربى التوت ولبه شديد الليونةالكبد يكون متضخما ويرقاني والحويصلة المرارية ممتلئة بعصارة صفراوية كثيفة ذات لون داكن كما قد توجد انزفة على الغشاء المخاطي لها أما الكلى فإنها تكون متضخمة ومحتقنة وذات لون داكن.توجد تغيرات انحلالية بالكلى والكبد و المثانة البولية غالبا ما تكون ممتلئة ببول لونه احمر إلى بنى داكنالرئتين غالبا ما تكون محتقنة وبها خذب. الغشاء المخاطي للمعدة الرابعة Abomasum والأمعاء قد يكون لونه اصفر يرقاني ويحتوى على انزفة أسفل الأغشية السيروزية. غشاء التامور Pericardium يكون مملوء بسوائل مصحوبة بانزفة دمويةوجود نقط نزيفية على القلب و المخفي الحالات تحت الحادة و المزمنةتكون ذبيحة الحيوان هزيلة ووجود اليرقان
![]() |
| Bovine, brain. The cerebral cortex is diffusely reddened (“cerebral flush”). |
![]() |
| Horse, heart and lungs. The trachea and pericardial fat are icteric. Lungs are irregularly congested and there is consolidation of the right cranioventral lung. |
![]() |
| Horse, kidney. The cortex is dark red due to hemoglobinemia. The medulla and pelvis exhibit icterus. |
التشخيص :· الأعراض التي تشمل الحمى وفقر الدم واليرقان والبول المحتوي على الهيموجلوبين إلى جانب تضخم الطحال وتحول لونه إلى اللون الداكن في أماكن توطن المرض والقراد الناقل يشي بتشخيص مبدئي للمرض، ويتم تأكيد هذا التشخيص المبدئي برصد الطفيل في المسحات الشريحية أو بالاختبارات الموجبة السيرولوجية أو تلك الخاصة بنقل العدوى تجريبيا في الحيوانات الحساسة للإصابة.· العينات اللازمة للفحوص المعملية: · من الحيوان الحي: يجب إعداد مسحات شريحية رقيقة وكثيفة ويفضل أن تكون من الشعيرات الدموية للأذن أو مؤخرة الذيل، كما يجب جمع عينات دم كامل على اديتا EDTA لفحوص الدم كما يجب جمع عينات مصل خلال الطور الحاد والطور النقاهة للاختبارات السيرولوجية.· عند عمل الصفة التشريحية من حيوانات لم يمر على نفوقها أكثر من 24 ساعة يجب عمل مسحات شريحية من عضلات القلب ومن الكلى والكبد والمخ ومن احد الأوعية الدموية الطرفية "مثل أسفل الأرجل". · يجب جمع عينات من القراد الناقل المتواجد على الحيوانات المريضة أو داخل الحظائر المصابة.· أكثر الطرق استخداما وشيوعا لتأكيد التشخيص هو الفحص الميكرسكوبى للمسحات الشريحية من دم أو أعضاء الحيوانات المريضة أو النافقة حديثا.· في الحالات الحادة، الطفيل عادة ما يمكن رصده في مسحات الدم الشريحية الرقيقة المصبوغة بصبغة جيمسا و المسحات السميكة تزيد من فرصة رصد الطفيل ولكن يصبح من الصعوبة بمكان تمييز التفاصيل المميزة لشكل الطفيل. في حالات الإصابة ببابيزيا أوفيس التي تتميز بانخفاض نسبة الخلايا المصابة السابحة في الدم Low parasitemias يكون ضروريا اخذ خزعات مخية Brain biopsies لتعظيم فرصة رصد الطفيل وتشخيص العدوى.

· في الحالات المزمنة التي تعقب الإصابة الحادة حيث يكون فيها الطفيل مختفيا أو متواجد بأعداد قليلة جدا فان التشخيص عادة ما يعتمد على رصد الأجسام المضادة للطفيل باختبارات سيرولوجية متنوعة.· الاختبارات السيرولوجية التي تستخدم لتأكيد التشخيص أو لمزيد من التفاصيل حول التشخيص تشمل: الاختبار الفلوروسنتي المضيء الغير مباشر IFAT الذي سوف يرصد الأجسام المضادة لكل من بابيزيا بوفيس وبابيزيا باىجيمنا ( إلى جانب كل من ثايليريا بوفيلاى، بابيزيا أو ثايليريا إيكواى).· اختبار الاليزا ELISA سوف يرصد الأجسام المضادة لكل من بابيزيا بوفيس، بابيزيا باىجيمنا (إلى جانب انابلازما سنترالي). اختبار الاليزا لبابيزيا بوفيس يعتبر اختبار تشخيص مسحي في حالة الأعداد الكبيرة من العينات وهو اختبار غير مباشر (يستخدم فيه مستضد خام لبابيزيا بوفيس يغطى به أطباق المعايرة الدقيقة) أما اختبار الاليزا لبابيزيا باىجيمنا فهو اختبار اليزا تنافسي Competitive ELISA يستخدم فيه مستضد معاد توليفه Recombinant antigen يغطى به أطباق المعايرة الدقيقة Microtitre plates.· مجسات الأحماض النووية DNA probes القادرة عل رصد اقل تواجد للطفيل كما هو الحال في الحالات الحاملة للعدوى Carrier animals تم استخدامها ولكن لم تدخل حيز الاستخدام العام بعد.· المسحات الشريحية من السائل الدموي الليمفي Hemolymph وكذلك من بويضات القراد Egg smears قد تستخدم للكشف عن العدوى بالقراد الناقل.· اختبار نقل العدوى تجريبيا للحيوانات القابلة للعدوى خاصة في العجول مستأصلة الطحال يعتبر إجراء مفيد ويتم الأخذ به لتأكيد الإصابة في الحالات المزمنة (والحالات الحاملة للعدوى ) التي يصعب تشخيصها حيث أن الأعراض تكون مبهمة مع غياب البول الهيموجلوبينى وانخفاض نسبة الأعداد المصابة من كرات الدم الحمراء. ويتم هذا الإجراء بحقنه بحوالي 500 ملل من دم الحيوان المشكوك به ثم مراقبته لظهور دلائل العدوى.· الفحوص الإكلينيكية للدم سوف تكشف عن انخفاض ملحوظ في عدد كرات الدم الحمراء وكذلك انخفاض حجم الخلايا المرصوصة Packed cell volume وانخفاض تركيز الهيموجلوبين إلى جانب زيادة وقت النزف Bleeding time وازدياد سرعة الترسيب لكرات الدم الحمراء.التشخيص المقارن :يجب ان نفرق بين عدوى البابيزيا و الامراض الاخرى و التي تحدث اعراض اليرقان و البول الدموي
| Clinical finding | epizootiology | disease |
| Fever,anorexia,lymph nodeenlargment, haemoglobinuria | Transimitted only by ticks of hyalomma spp. | Tropical theileriosis |
| Haemolytic disease mostly in young calvesHigh fever, sudden onest of septicaemia with red urine, mloody thick milk,abortion,mucosal petechiae,jaundice,red urine | All age, calves high mortality 50% adults low mortality less than 5% | leptospirosis |
| Often found dead .very acute onest. Fever,abdominal pain.haemolytic anaemiaDiarrhea,shallow rapid respiration red brown urine with no cells | Usually mature cattle during summer time on irrigate pasture in enzootic areaSporadic cases with 100% mortality | Bacillary haemoglobin urea |
| Acute onest no fever no change in milk no jaundice.weakness ,tremor,pallor,bounding pulse , loud heart sound,tachycardia,hb uria,deep brown to black frothy urine.long convalescence.mortality 50% | Post caving 2-4 weeksHigh producing cow in 3rd-6th lactation.Low phosphorus diet | Postparturient hb uria |
| Sudden onest no fever and jaundice.weakness ,tremor,pallor, ,hb uria | increase feeding or administrate drug containing copper | Chronic copper poisoning |
الوقاية :
مكافحة القراد باستخدام المبيدات الحشرية وتطعيم القطعان الحساسة للإصابة والوقاية بالعلاج الكيميائي Chemoprophylaxis إلى جانب علاج الحالات المريضة والتحكم في حركة القطعان الحاملة للقراد والعدوى كما يمكن اختيار السلالات المقاومة للقراد للتربية. يمكن استخدام إجراء أو أكثر من الإجراءات السابقة حسب الوضع الوبائي للمنطقةمبيدات القراد شائعة الاستخدام لمكافحة القراد تشمل مركبات الهيدروكربونات الكلورنية Chlorinated hydrocarbons والكارباميت Carbamates ، المركبات الفسفورية العضوية Organophosphates ومركبات البيرثيرين الطبيعية والمخلقة Pyrethrins إلى جانب عقاقير الحقن مثل الايفرميكتين Avermectins. مبيدات القراد غالبا ما يتم استخدامها عن طريق التغطيس أو الرش وان كان التغطيس هو الأكثر فعالية. حديثا وفي السنوات القليلة الماضية تم استخدام وسائل أخرى لاستخدام مبيدات القراد مثل الصب "pour-ons" حيث يتم صب المبيد على ظهر الحيوان فيتم امتصاصه أو الدهن على بقعة محدودة من ظهره "spot-ons"حيث يتم امتصاص العقار من خلالها.

ساحة النقاش